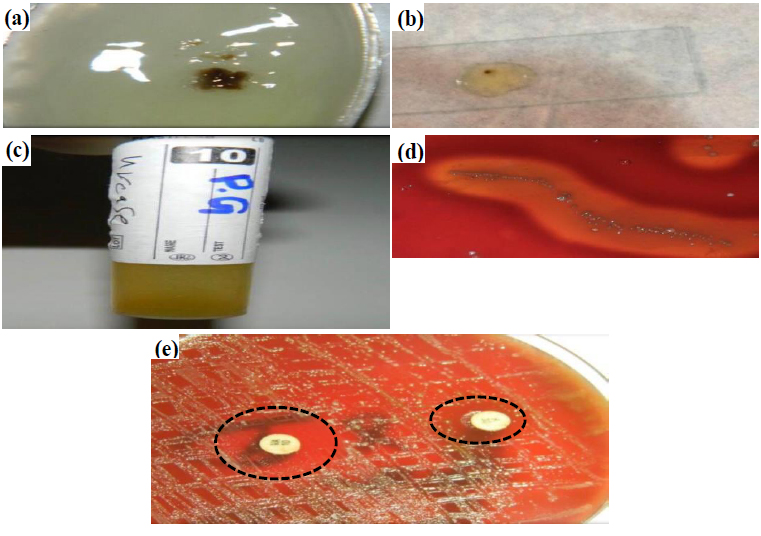

All published articles of this journal are available on ScienceDirect.
Determination of Antibacterial Activity of Commiphora Myrrha and Ziziphus spina-christi Leaf Extracts Against Porphyromonas gingivalis in Patients with Fixed Partial Dentures with Chronic Periodontitis - An In Vitro Study
Abstract
Introduction
Porphyromonas gingivalis (P. gingivalis), a highly studied black pigmented bacterium, is thought to be associated with chronic periodontitis. It makes up a significant portion of the subgingival microbiota found in periodontal pockets. Natural antibacterial compounds derived from plants could be potential substitutes for the traditionally employed chlorhexidine. Thus, the aim of this study was to investigate the antibacterial properties of alcoholic extracts from the leaves of Ziziphus spina-christi (ZSC) and Commiphora myrrha (C. myrrha) in vitro, both individually and in combination, against the P. gingivalis.
Materials and Methods
Clinical samples of subgingival plaque were taken from patients who had fixed partial dentures with chronic periodontitis. The presence of the target microorganism was verified via Gram's stain and biochemical tests. Ethanol extracts were prepared from the leaves of ZSC and C. myrrha in vitro. Antibacterial effects of different concentrations of the olive leaf extracts (20%, 40%, 60%, 80% and 100%) were tested both individually and in combination, against the P. gingivalis, and compared with those of deionized water and 0.2% chlorhexidine gluconate. The minimum inhibitory concentration (MIC), minimum bactericidal concentration (MBC), and susceptibility of the bacteria to the extracts were measured both individually and in combination.
Results
P. gingivalis growth was significantly inhibited by ethanol extracts at different concentrations (20%, 40%, 60%, 80% and 100%), resulting in varying degrees of growth inhibition. Researchers have demonstrated that a combination of extracts (Commiphora myrrha and Ziziphus spina-christi leaf extracts) has greater antibacterial effects than chlorhexidine, followed by individual extracts from C. myrrha and ZSC. The MICs of the extracts varied between 0.2 and 0.6 g/ml. The alcoholic extracts had MBCs ranging from 0.4 to 0.8 g/ml.
Discussion
A prevalent public health issue, periodontal diseases have little chance of being prevented. Therefore, it is crucial to look for possible substitutes for synthetic substances. These plants' or their extracts' antibacterial properties may serve as a source for novel antibiotics.
Conclusion
Each extract exhibited both bacteriostatic and bactericidal properties and was effective against P. gingivalis. The combined alcoholic extract had the strongest antibacterial activity against P. gingivalis at all the tested concentrations. Therefore, it can be considered a potential alternative to chlorhexidine.
1. INTRODUCTION
The accumulation of biofilm at the gingival line of the tooth surface triggers an inflammatory response known as periodontal disease [1-3]. According to the classification system proposed by the American Academy of Periodontology, periodontal diseases are classified into two basic categories, namely, gingivitis and periodontitis, according to whether the periodontal attachment has been damaged [4]. The inflammatory process of the gingiva is thought to be a predisposing factor for periodontitis; hence, treating gingivitis is crucial for the principal prevention of this disease [4-7]. Over 50% of adults worldwide suffer from periodontitis, a condition that worsens with advancing age. The 2010 Global Burden of Diseases Study recognized severe periodontitis as the sixth most common human disease and a major contributor to tooth loss [8, 9]. Severe periodontitis poses a serious public health risk since it negatively affects speech, diet, confidence, quality of life, and oral health. It is also independently linked to a number of systemic chronic inflammatory disorders [10-13]. A typical therapy for partially edentulous ridges is a fixed partial denture (bridge), which is an excellent way to replace missing teeth. However, the stability and health of the surrounding periodontal system are crucial for bridge effectiveness [14]. A substantial amount of research has shown that having permanent prosthetic restorations is associated with a greater risk of periodontal disease [11]. Periodontal health has a major impact on the durability of prosthodontic restorations. On the other hand, a poorly designed prosthesis may accelerate the development of periodontal disease [15, 16].
Many bacteria are thought to be linked to chronic periodontitis [1, 4, 17, 18]. The primary species involved in the development of chronic periodontitis is P. gingivalis [19-22], which can be detected in up to 85% of periodontitis cases [4]. They are rod-shaped, gram-negative, non-motile, black-pigmented, opportunistic species that require anaerobic growth conditions, as well as the presence of vitamin K and heme or hemin in their nutritional environment [18, 23]. This ability is necessary for survival in deep periodontal pockets where carbohydrates are extremely scarce [19]. P. gingivalis is one of three bacterial associations known as the “red complex,” which also includes the gram-negative bacteria Tannerella forsythia and Treponema denticola. Recent research has revealed that P. gingivalis is the primary pathogen within the red complex, contributing to microbial imbalance and causing disease progression [5, 19, 24, 25].
The first step in the treatment of periodontal disorders is to manage the buildup of dental plaque linked to scaling and root planning, which enables the removal of calculus and biofilm [26]. Since systemic antibiotics may fail to control the severity of the disease, they are currently exclusively recommended for the treatment of rapidly progressing periodontitis. Numerous systemic antibiotics have shown a number of side effects, including high peak plasma antibiotic concentrations, the emergence of microbial resistance, rapid decreases in antibiotic concentrations to subtherapeutic levels, insufficient antibiotic concentrations at the periodontal pocket site, high incidences of allergies, and increased costs. The fact that some periodontal bacteria can enter host cells is another element that works against antibiotics [1, 2].
The identification of new antibacterial chemicals has become a key priority in recent years because of the difficulty in developing effective strategies for treating chronic periodontitis [1, 27]. Since plant-derived products are a source of chemical agents with antibacterial qualities, they have been utilized for medical purposes for several years [28-30]. Owing to their long history of use in traditional medicine and their natural, non-chemical, and non-synthetic nature, significant herbal extracts have drawn attention [31]. Flavonoids, polyphenols, and alkaloids are among the compounds found in many plants used in traditional medicine. One such plant is Commiphora Myrrha (C. Myrrha), which was introduced as an analgesic for toothaches and as an antiseptic in toothpastes and mouthwashes [32]. The antibacterial activity of these plants suggests possible sources for the development of novel antibiotics [33-35]. Another common plant, Ziziphus spina-christi (Z. spina-christi), is a plentiful and reasonably priced source of novel antibacterial compounds [36-38]. Z. spina-christi has been used as an alternative medicine for many years to treat inflammatory problems, fever, pain, dandruff, wounds, ulcers, and eye diseases [39]. Recent research has demonstrated the antibacterial, antifungal, antioxidant, and antihyperglycemic properties of Z. spina-christi.
This study investigated the potential antibacterial properties of extracts from C. myrrha and Ziziphus spina-christi leaves (ZSCs) against P. gingivalis, a bacterium that is one of the primary inhabitants of dental plaque. The null hypothesis was stated that there is no significant antibacterial effect of the tested extract on P. gingivalis.
2. METHODOLOGY
2.1. Selection of Patient and Sample Technique
Fifteen healthy people with fixed dental partial bridges and chronic periodontitis, aged between 35 and 55 years, were selected systematically and included in the study. Pregnancy status, smoking status, use of anti-inflammatory or antibiotic medications through the last three months, and any periodontal or professional cleaning within the last six months were the basis for the exclusion criteria. Samples of subgingival plaque were taken from patients who attended the periodontics clinic at the teaching hospital of Kufa University's Faculty of Dentistry, where the depth of the probing pocket (PPD) of the abutment of a fixed partial denture was at least 6 mm.
The samples were collected from March 2024 to April 2024, and the present in-vitro study was conducted at Kufa University's faculty of dentistry. The protocol of this study was ethically approved by the Medical Ethical Committee, College of Medicine, University of Kufa (reference #MEC-26, Date 15/3/2024). The patients were informed of the study's objective and provided their consent before being included. To eliminate supragingival plaque, the tooth was sprayed with water and then air-dried. To prevent salivary contamination, the area was sealed with cotton rolls. The subgingival plaque was carefully removed from the depth of the pocket using periodontal Gracey curettes so as not to damage nearby tissue. Less than 30 minutes after sample collection, the subgingival plaque was placed on a swab and directly transferred into the transfer medium to preserve the sample.
After that, the samples were incubated on blood agar media for 72 hours at 37°C in an anaerobic jar and anaerobic gas packs. Then, the bacteria were identified based on their microscopic appearance, colony shape and size, presence of Gram-stained bacteria, and the outcomes of biochemical testing, including those for urease, hemolytic capacity, catalase, and antibiotic susceptibility. To obtain pure cultures of P. gingivalis for the purpose of detecting the inhibition zone, colonies were subcultured once more on the same media under anaerobic conditions for a duration of 72 hours, following the same protocol.
2.2. Preparation of Culture Media
2.2.1. Blood Agar
In accordance with the guidelines provided by the manufacturer, a blood agar base (beef heart infusion from beef extract, sodium chloride, tryptose, and agar) was made by suspending 40 grams in 1000 milliliters of distilled water (D.W.). The medium was then heated to the boiling point for 5 minutes to completely dissolve it, after which it was autoclaved for 15 minutes at 121°C for sterilization. After the medium was cooled to approximately 50°C, 5% sterile blood was aseptically added and thoroughly mixed, and the medium was then poured into sterile Petri dishes under an ultraviolet (UV) sterilization hood.
2.2.2. Porphyromonas Gingivalis Agar
Powdered selective medium made of Colombian blood agar combined with vitamin K, bacteriocin, and antibiotics (clindamycin) was used. A complete medium dissolves when twenty grams of the powder is suspended in 500 millilitres of D.W. and heated to the boiling point. The media were subsequently autoclaved for 15 minutes at 121°C to sterilize them. They were then allowed to cool to approximately 50°C before being aseptically mixed in 50 ml of sterile blood and placed into sterile Petri dishes under a UV sterilization hood.
2.2.3. Thioglycolate Broth Liquid Media Suitable for Anaerobic Microorganisms
Yeast extract, tryptone, glucose, sodium thioglycolate, sodium chloride, L-cystine, resazurin, and agar were the ingredients in the thioglycolate powder. A total of 29.75 grams of the powder was mixed in 1 liter of D.W. Then, the mixture was completely boiled and autoclaved at 121°C for 15 minutes. The mixture was then permitted to cool to approximately 25°C before being refrigerated.
2.3. Extraction Procedures
At the Ibn-AL-Betar Research Center, a division of the Ministry of Industry and Minerals, the procedure for extracting ZSC leaves andC. Myrrha was completed (Fig. 1). ZSC leaves were collected from farms in the city of Najaf. The procedure suggested by Temerk et al. [40, 41] was used to produce extracts from ZSC leaves. The ZSC leaves were subsequently allowed to air dry at room temperature after being cleaned with tap water and then distilled water. Using an electric blender, the dried leaves were ground into a coarse powder and stored in a dry, clean container for later use. ZSC leaves weighing 100 grams were dissolved in 500 ml of 70% ethanol. A filter paper (WhitmanTM no. 1) was used to filter the solution after it had been shaken for eight hours at room temperature with the aid of a shaker. The filtrate was allowed to dry completely at room temperature to evaporate any remaining solvent. The resulting powder was then collected and stored at room temperature in a tightly sealed, dark glass container until solutions with different concentrations were obtained.
Myrrha and oleo-gum-resin from Commiphora myrrha (C. Myrrha) were purchased from a standard commercial source (Najaf, Iraq). The materials were divided into smaller parts, cleaned with distilled water, and then dried at 37°C in an incubator. They were subsequently ground into a fine powder using an electric blender [41]. The resin was filtered through WhatmanTM no. 1 filter paper after it had been ground to a particle size of 100 gm and allowed to percolate in 70% ethanol concentrated at 40–60°C for eight hours in a sonic bath. A rotary evaporator was used to extract the solvent under vacuum. After that, the mixture was dried even more using a hot air oven at 40°C. The thick sticky paste that was produced was then stored in a refrigerator until it was needed to make solutions with various concentrations [42].

(a) Leaves of Ziziphus spina-christi and (b) Myrrha resin.
The extracts were stored for no longer than one month, as longer storage times caused the C. Myrrha and ZSC extracts to lose some of their inhibitory effects [43]. Dimethyl sulfoxide (DMSO) was used to dissolve the extracts to various concentrations for the alcoholic C. Myrrha and ZSC extracts. A vortex mixer was used to create homogeneous solutions. Both extracts were treated in the same way, and the results are as follows.
To obtain a 20% concentration, (1 gm) of the extract was dissolved in 5 ml of DMSO.
To obtain a 40% concentration, (2 gm) of the extract was dissolved in 5 ml of DMSO.
To obtain a 60% concentration, (3 gm) of the extract was dissolved in 5 ml of DMSO.
To obtain an 80% concentration, (4 gm) of the extract was dissolved in 5 ml of DMSO.
To obtain a 100% concentration, (5 gm) of the extract was dissolved in 5 ml of DMSO [44].
To create a 20% concentration combination mixture, the mixing procedure described by Stephenson [45] began with the addition of 1 mL each of the alcoholic C. Myrrha and ZSC leaf extracts from their corresponding 20% concentrations, then creating homogeneous solutions via a vortex mixer. This process was repeated to create other concentrations of the combination mixture.
2.4. Experiments of the Study
2.4.1. Experiment No.1
To evaluate the sensitivity of P. gingivalis to the ZSCL and alcoholic Myrrha separately and in Combination, these experiments were conducted using four isolates of P. gingivalis. The disk diffusion technique was applied to study the antibacterial effects of varied conc. of C. Myrrha and ZSCL extracts (20%, 40%, 60%, 80%, 100%) separately and in combination compared with deionized water (D.W.) as a negative control and chlorhexidine gluconate 0.2% as a positive control.
2.4.1.1. Procedure
Using a sterile loop, three colonies were selected from the pure culture plate and spread onto a blood agar plate in a mattress fashion. Afterward, wells of uniform size and depth were prepared in the agar using a Pasteur pipette, which had been sterilized by direct flame. Each well was then filled with 100 microliters of the selected agent. The plates were incubated anaerobically for 48 hours.
The diameter of the inhibition zone around each well was measured in millimeters using a ruler. A zone of inhibition indicates a clear area around the well where no bacterial growth is present, demonstrating the effectiveness of the agent. In contrast, the absence of a zone of inhibition indicates complete resistance of the bacteria to the tested agents.
2.4.2. Experiment No. 2
Determination of minimum inhibitory concentration (MIC) and minimum bactericidal concentration (MBC) of ZSCL extracts and alcoholic C. Myrrha was carried out separately and together against P. gingivalis by serial micro dilution procedure. The first serial dilution method was used to standardize the bacterial inoculum. This experiment included three study groups and was conducted on four isolates of P. gingivalis, which were:
Group A: Alcoholic C. Myrrha extract against P. gingivalis.
Group B: Alcoholic ZSCL extract against P. gingivalis.
Group C: ZSCL extracts and alcoholic C. Myrrha in combination against P. gingivalis.
For each study group, there was a negative control (D.W.) and a positive control, which was CHX gluconate 0.2%.
2.4.2.1. Procedure
2.4.2.1.1. Serial Microdilution
A sterile microtiter (96-well plate) was prepared near an alcohol burner in an aseptic atmosphere for the serial dilution method to standardize. Using a micropipette, 150 µl of fresh thioglycolate broth was dispersed into one of the microtiter plate wells. Using a flamed loop, cooled at the corner of an agar plate, a colony of each microorganism was chosen and then inserted into a well, one for each organism. After that, we used the micropipette to transfer 15 µl from the first well and placed it into the next well. We then completed the other 135 µl with fresh thioglycolate broth to achieve a total volume of 150 µl. The procedure was repeated 5 times in 5 consecutive wells to obtain 5 serial dilutions of a 1:10 ratio each time. Each well was stamped with the number of its dilution (e.g., zero for the first well, 5 for the 5th dilution well, and so on).
2.4.2.1.2. Determination of MIC
Tubes of Appedroff were labeled and regulated in a rack. For each tube, 100 µL of bacterial suspension was added, followed by the addition of 50 µL of the tested agent to its designated tube. Then, anaerobic incubation for 72 hours was performed on the the tubes. Following incubation, the tubes were checked to evaluate the presence of any turbidity, which would indicate bacterial growth. Tubes that lacked turbidity were identified as the MIC, while those exhibiting turbidity signs were excluded.
2.4.2.1.3. Determination of MBC
Asubculture was made from the tubes that were identified as the MIC in order to estimate the MBC. A volume of 150 µl was picked up from each tube utilizing a micropipette and spread on a blood agar plate with a sterile spreader and incubated anaerobically for 48 hours. After the incubation period, the plates were removed and checked for bacterial growth. The plates that showed no growth were identified as the minimum bactericidal concentration.
2.5. Statistical Analysis
The statistical analysis was performed with the social science statistical package version 22.0 of the SPSS statistical software program (IBM Corp., Armonk, USA). The mean and standard deviation of the data were obtained. The level of significance was set at 0.05. The inhibition zones at different concentrations for each type of extract were statistically analyzed using independent sample t tests and one-way analysis of variance (ANOVA).
3. RESULTS
3.1. Identification of Porphyromonas Gingivalis
3.1.1. Colony Morphology
P. gingivalis colonies were inspected and identified on the blood agar plates. The colonies had a raised or convex surface, with spherical shape, black pigmentation, and firm attachment to the agar surface (Fig. 2a). Pg cells were revealed under a microscope to be gram-negative (red in color) rods arranged in short or medium-length chains (Fig. 2b).
3.1.2. Biochemical Tests
A- When Porphyromonas gingivalis colonies were tested with catalase, no bubbles surrounded them, indicating that the colonies were catalase negative (Fig. 3a). No coagulation of human serum was detected using the B-coagulase test, revealing coagulase negativity (Fig. 3b). After 72 hours of incubation, P. gingivalis revealed no change in the yellow color of the urea solution during the C-Urease test, indicating that the colonies were urease negative (Fig. 3c). When P. gingivalis colonies were grown on blood agar, clear zones were observed around them, revealing the hemolytic ability of Pg (Fig. 3d). The antibiotic disks had inhibition zones surrounding them, indicating that Pg was susceptible to both vancomycin and kanamycin (Fig. 3e).
3.2. Determining the Diameter of the Bacterial Inhibition Zones
In vitro sensitivity of P. gingivalis to various concentrations of alcoholic C. myrrha, ZSC leaves, and extract mixtures was evaluated. At 20% and 40% concentrations of the ZSC extract, no bacterial inhibition zones (BIZs) were observed, and the BIZ increased as the extract concentration increased.

(a) Pg on a blood agar plate and (b) microscopic appearance and Gram stain of Pg (1000×).
(a) Catalase negative, (b) coagulase negative, (c) urease negative, (d) hemolytic ability, and (e) antibiotic sensitivity of Pg.
The ZSC extract had lower mean values of the BIZ than CHX, and C. myrrha combination extracts presented greater mean values than CHX at 60%, 80%, and 100% confluence. D.W. showed no BIZ, but 100% of the combination extracts had a maximum mean BIZ of 11.04 mm overall. Significant differences were detected between the various extract concentrations, both alone and in conjunction with CHX and DW, using a a one-way ANOVA test (Table 1). Statistically significant differences were found at all concentrations when Myrrha, Ziziphus, and combination extracts were compared between each pair of different concentrations (Table 2). There were statistically significant differences between CHX and D.W. at each concentration of C. myrrha, ZSC, or the combination extracts (Table 3). There were no significant differences only at 20% and 40% of ZSC.
| Agents | Conc. | Mean | ±S.D. | ANOVA Test |
|---|---|---|---|---|
| CHX | 0.2% | 7.03 | 0.09 | - |
| D.W. | - | 0 | 0 | - |
| Myrrha extract | 20% (0.2 g/ml) | 3.43 | 0.44 | - |
| 40% (0.4 g/ml) | 4.23 | 0.14 | F=923.187 | |
| 60% (0.6 g/ml) | 7.15 | 0.13 | P=0.00 S | |
| 80% (0.8 g/ml) | 9.35 | 0.27 | d.f.=22 | |
| 100% (1 g/ml) | 10.24 | 0.25 | - | |
| CHX | 0.2% | 7.03 | 0.08 | - |
| Ziziphus extract | 20% (0.2 g/ml) | 0 | 0 | - |
| 40%(0.4 g/ml) | 0 | 0 | F=297.76 | |
| 60% (0.6 g/ml) | 1.13 | 0.08 | P=0.00 S | |
| 80% (0.8 g/ml) | 3.03 | 0.06 | d.f.=22 | |
| 100% (1 g/ml) | 6 | 0.01 | - | |
| D.W. | - | 0 | 0 | - |
| Combination extracts | 20% (0.2 g/ml) | 4.26 | 0.05 | - |
| 40% (0.4 g/ml) | 6.21 | 0.140 | F=216.482 | |
| 60% (0.6 g/ml) | 8.16 | 0.220.09 | P=0.00 S | |
| 80% (0.8g/ml) | 10.14 | 0.200 | d.f.=22 | |
| 100% (1 g/ml) | 11.04 | 0.07 | - |
| Conc. | Myrrha Extract | Ziziphus Extract | Combination Extracts | ||||
|---|---|---|---|---|---|---|---|
| Mean Difference | p-value/Sig | Mean Difference | p-value/Sig. | Mean Difference | p-value/Sig. | ||
| 20% | 40% | -0.872 | 0.00 HS | 1.25 | 0.00 HS | -2.07 | 0.00 HS |
| - | 60% | -2.74 | 0.00 HS | 1.13 | 0.00 HS | -4.05 | 0.00 HS |
| 80% | -5.93 | 0.00 HS | 3.04 | 0.00 HS | -5.98 | 0.00 HS | |
| 100% | -6.92 | 0.00 HS | 5.01 | 0.00 HS | -6.91 | 0.00 HS | |
| 40% | 60% | -1.95 | 0.00 HS | -1.14 | 0.00 HS | -1.98 | 0.00 HS |
| - | 80% | -5.04 | 0.00 HS | -3.04 | 0.00 HS | -3.88 | 0.00 HS |
| 100% | -6.05 | 0.00 HS | -5.23 | 0.00 HS | -4.81 | 0.00 HS | |
| 60% | 80% | -3.04 | 0.00 HS | -1.91 | 0.00 HS | -1.91 | 0.00 HS |
| - | 100% | -4.08 | 0.00 HS | 3.88 | 0.00 HS | -2.83 | 0.00 HS |
| 80% | 100% | 1.00 | 0.00 HS | 1.98 | 0.00 HS | -0.93 | 0.00 HS |
| Extracts | Concentration | BIZ-CHX 0.2% | BIZ-D.W. |
|---|---|---|---|
| p-value | p-value | ||
| C. myrrha | 20% (0.2 g/ml) | 0 | 0 |
| 40%(0.4 g/ml) | 0 | 0 | |
| 60%(0.6 g/ml) | 0 | 0 | |
| 80% (0.8 g/ml) | 0 | 0 | |
| 100% (1 g/ml) | 0 | 0 | |
| ZSC | 20%(0.2 g/ml) | 0 | 1 |
| 40%(0.4 g/ml) | 0 | 1 | |
| 60%(0.6 g/ml) | 0 | 0 | |
| 80% (0.8 g/ml) | 0 | 0 | |
| 100% (1 g/ml) | 0 | 0 | |
| Combination | 20% (0.2 g/ml) | 0 | 0 |
| 40%(0.4 g/ml) | 0 | 0 | |
| 60%(0.6 g/ml) | 0 | 0 | |
| 80%(0.8 g/ml) | 0 | 0 | |
| 100% (1 g/ml) | 0 | 0 |
| Concentration | BIZ-C. Myrrha Extract | BIZ-Combination Extracts | p-value | BIZ-ZSC Extract | BIZ-Combination Extracts | p-value |
|---|---|---|---|---|---|---|
| Mean ±S.D. | Mean ±S.D | Mean ±S.D | Mean ±S.D. | |||
| 20% (0.2 g/ml) | - | - | 0.064 | - | - | 0 |
| 3.43 ± 0.44 | 4.26 ± 0.05 | 0 ± 0 | 0.05 ± 4.26 | |||
| 40% (0.4 g/ml) | - | - | 0 | - | - | 0 |
| 4.23 ± 0.14 | 6.21± 0.140 | 0 ± 0 | 0.140 ± 6.21 | |||
| 60% (0.6 g/ml) | - | - | 0 | - | - | 0 |
| 7.15 ± 0.13 | 8.16 ± 0.22 | 1.13 ±0.08 | 0.22 ±8.16 | |||
| 80% (0.8 g/ml) | - | - | 0.004 | - | - | 0 |
| 9.35 ± 0.27 | 10.14 ± 0.20 | 3.03 ± 0.06 | 0.20 ± 10.14 | |||
| 100% (1 g/ml) | - | - | 0.002 | - | - | 0.002 |
| 10.24 ± 0.25 | 11.04 ± 0.07 | 6 ± 0.01 | 0.07 ± 11.04 |
| Combination Extracts | Ziziphus Extract | Myrrha Extract | Bacteria | |||
|---|---|---|---|---|---|---|
| MBC | MIC | MBC | MIC | MBC | MIC | |
| 40% (0.4 g/ml) | 20% (0.2 g/ml) | 80% (0.8 g/ml) | 60% (0.6 g/ml) | 40% (0.4 g/ml) | 20% (0.2 g/ml) | P. gingivalis |
Overall, the comparisons shown in Tables 4 and 5 revealed that the combination extracts had the highest mean BIZ values against P. gingivalis at all concentrations, followed by the C. myrrha extracts, and finally the ZSC extracts. Therefore, statistically significant differences were detected at all concentrations, except for the non-significant difference at the 20% concentration between Myrrha and the combination extracts.
3.3. MIC and MBC
The MIC and MBC of alcoholic C. Myrrha and the combination extracts were the same (20% or 0.2 g/ml and 40% or 0.4 g/ml, respectively), whereas those of the ZSC extract were 60% (0.6 g/ml) and 80% (0.8 g/ml), respectively (Table 5).
4. DISCUSSION
Commiphora myrrha has been approved as a safe natural flavoring agent for food and beverages, as well as a fragrance ingredient for cosmetics [46, 47]. Studies have shown that mouthwashes and toothpastes containing C. myrrha are effective in treating and preventing gingivitis [33, 48]. A diluted C. myrrha suspension aided in the healing and repair of animal tissues damaged in the mouth, according to one study [49].
On the other hand, ZSC leaf extracts have been employed as anti-inflammatory agents for toothache and eye washing [50]. The antibacterial activity of the anaerobic periodontal pathogen P. gingivalis, which was isolated from subgingival plaque, was compared with that of 0.2% CHX gluconate and various concentrations of C. myrrha and ZSC leaf extracts in this study. Importantly, this study's findings may be the first to demonstrate that the introduced herbal mixture has never been prepared and examined for its effect on P. gingivalis.
Despite their widespread availability, a number of chemical agents may alter the oral microbiota and result in undesirable side effects, such as tooth staining [51]. Owing to their ability to function as adjunctive therapies as well as preventative measures against plaque development, the use of herbal components is also gaining popularity. Numerous studies have examined the antibacterial effects of C. myrrha or ZSC alone on herbal preparations [52-54]; however, their combined effects on lowering microbial counts and plaque formation have not yet been investigated. While this study focused on bacteria linked to chronic periodontitis, other in vitro studies [44, 55, 56] have examined the activity of natural plant substances against oral bacteria and have unambiguously established anticariogenic activity against bacteria associated with periodontal diseases.
According to the results of this study, there was a significant antibacterial effect for the tested extracts. Therefore, the null-hypothesis was rejected. According to the findings of this study, the diameter of the BIZ also increased as the extract concentration increased. This occurred because the antimicrobial activity of the extracts increased as a result of an increase in the amount of dissolved active antibacterial components. According to the mean values of IZ, the combination extracts (60%, 80%, and 100% conc.) against P. gingivalis were the most effective antimicrobial agents. Compared with CHX and ZSCC. Commiphora myrrha was the next most effective agent (60%, 80%, and 100% conc.).
Referring to phytochemical analyses of oleogum resins [57], sesquiterpenes and furanosesquiterpenes are two of the main constituents of C. myrrha. Since a sesquiterpenoid found in C. myrrha is thought to play a major role in antibacterial activities, these results verified the antibacterial activity of the gum resins [58, 59]. Sesquiterpenes have bactericidal rather than bacteriostatic antimicrobial effects; they interact with the cell envelope to cause bacterial lysis and subsequent lethal loss of intracellular material [60], while phytochemical analysis [61], suggested that the antibacterial activity of plant species might be attributed to the presence of alkaloids, carbohydrates, and saponins found in C. myrrha extracts.
Tannins are another important element that affects the function of bacteria and enzymes [62]. Further studies have shown that the inhibitory impact of Myrrha extract might be due to the presence of large single terpene molecules known as volatile oils. The ability of these oils to modify the cell wall also weakens the biological activity of the cell by causing it to overlap with the cytoplasmic membrane. This is demonstrated by the ability of these oils to impede and halt the synthesis of new proteins, which prevents ions and salts from actively passing across this membrane [63]. Furthermore, a significant study [64, 65] revealed that Myrrha would have good antibacterial effects if it contained secondary metabolites, such as flavonoids, alkaloids, tannins, and glycosides, as well as flavonoid tannins, glycosides, and saponins. According to a different study, these plants' phenolic compounds may have antimicrobial properties [66].
While P. gingivalis was sensitive to various alcoholic ZSC concentrations (apart from 0.2 g/ml and 0.4 g/ml, which had no antibacterial effects), its IZ values were lower for 0.6 g/ml, 0.8 g/ml, and 1 g/ml than for 0.2% CHX; however, since 0.2% CHX is a natural herb, it was thought to be superior. Sider leaf extracts were shown to have inhibitory effects on S. faecalis at concentrations as high as 50 mg/ml, and at 200 mg/ml, IZ (13.33 mm) was found [67]. According to a different study [68], when combined with (13 mm) IZ, the ethanolic extract of Sider leaves had the highest activity against gram-positive bacteria at a dosage of 128 mg/L, whereas (8 mm) IZ had the lowest activity. These results revealed that the antibacterial effectiveness of the Sider ethanolic extract against the tested microorganisms increased when it was used at greater concentrations. Others have reported that the presence of multiple active ingredients, including flavonoids, phenolic compounds, alkaloids, and essential oils, is the reason behind the action of ZSC extracts [54]. Owing to the presence of active antimicrobial constituents that are sufficient to inhibit growth and damage the isolated bacteria to a degree that is comparable to that of CHX, the diameters of BIZ produced by the combination extracts and Myrrha at 60%, 80%, and 100% concentrations were significantly greater than those produced by 0.2% CHX for P. gingivalis. As a result, the use of C. myrrha alone or in combination with ZSC extracts produces antibacterial effects that may be a good substitute for CHX.
When the C. Myrrha extract was mixed with the other extracts, the MIC was 20%; however, the ZSC extract had an MIC of 60%. Plant extracts with MICs of less than or equal to 0.5 mg/ml demonstrated good antibacterial activity. Consequently, the ethanol extracts of C. myrrha and the combined extracts demonstrated strong antibacterial activity against P. gingivalis.
The alcoholic C. Myrrha extract exhibited a bactericidal effect against P. gingivalis, as evidenced by the MBC of 0.4 g/ml required to kill the pathogen. While the MBC of the combination extracts that killed P. gingivalis isolate growth was 40% (0.4 g/ml), indicating the bactericidal effect of the combination extracts, the MBC of the ZSC leaf extract that killed P. gingivalis isolate growth was 80% (0.8 g/ml), indicating that the agent demonstrated a bactericidal effect. The MBC of the ZSC leaf extract against P. gingivalis was greater than that of C. Myrrha and the combination extracts. This difference may have resulted from the active antibacterial properties of the ZSC extract, which might only be present at high bacterial concentrations.
One of the limitations of this study is the use of a limited number of bacterial types. Another limitation was the testing of only the antibacterial effect of alcoholic extracts of the tested herbals. Therefore, for future work, the suggestions include the application of this extract and an aqueous extract on various types of bacteria. Moreover, an in vivo study of the antiplaque effects and the substantivity of alcoholic C. Myrrha, ZSCL, and combination extracts as a mouth rinse, periodontal pocket irrigation, or gel on the improvement of periodontal health status, expressed through effects on plaque, gingival, and bleeding indices in patients with periodontal disease, is recommended. Additionally, the effect of combination extracts as a gel on bacterial count in implant screw cavities should be studied. Further investigations concerning the safety and toxicity of C. Myrrha and ZSCL extracts are also necessary.
CONCLUSION
Combination extracts of Ziziphus spina-Christi (ZSC) and Commiphora myrrha (C. myrrha) have been found to be more effective than individual leaf extracts against P. gingivalis. As a result, they could be used in place of CHX to verify their effectiveness. The antimicrobial properties of C. myrrha and ZSC extracts as P. gingivalis inhibitors require additional in vitro and in vivo research. Due to their antimicrobial effects, these natural materials are suitable for use in toothpaste, mouthwash, and other products that help treat periodontal diseases. Notably, the inhibitory effects of C. myrrha and ZSC extracts decreased with increasing storage time.
AUTHORS' CONTRIBUTIONS
The authors confirm their contributions to the paper as follows: A.A.: Study conception and design; R.H. and M.S.: Data collection; N.A.: Data analysis or interpretation; R.A.: Methodology; S.S., A.A., and S.A.N.: Draft manuscript. All authors reviewed the results and approved the final version of the manuscript.
LIST OF ABBREVIATIONS
| D.W. | = Distilled Water |
| UV | = Ultraviolet |
| ZSC | = Ziziphus spina-Christi |
| BIZs | = Bacterial Inhibition Zones |
| PPD | = Probing Pocket Depth |
ETHICS APPROVAL AND CONSENT TO PARTICIPATE
The protocol of this study was ethically approved by the Medical Ethical Committee, College of Medicine, University of Kufa, Iraq (reference #MEC-26, Date 15/3/2024).
HUMAN AND ANIMAL RIGHTS
All human research procedures followed were in accordance with the ethical standards of the committee responsible for human experimentation (institutional and national), and with the Helsinki Declaration of 1975, as revised in 2013.
AVAILABILITY OF DATA AND MATERIALS
The data supporting the findings of the article will be available from the corresponding author [R.H] upon reasonable request.
ACKNOWLEDGEMENTS
The authors are extremely appreciative of Dr. Julfikar Haider for his valuable contributions and guidance in preparing this study.

